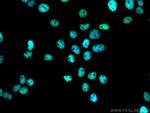
RALY Antibody in Immunocytochemistry (ICC/IF)

Search
Proteintech
RALY Monoclonal Antibody (2B10C3), CoraLite® Plus 488
{{$productOrderCtrl.translations['antibody.pdp.commerceCard.promotion.promotions']}}
{{$productOrderCtrl.translations['antibody.pdp.commerceCard.promotion.viewpromo']}}
{{$productOrderCtrl.translations['antibody.pdp.commerceCard.promotion.promocode']}}: {{promo.promoCode}} {{promo.promoTitle}} {{promo.promoDescription}}. {{$productOrderCtrl.translations['antibody.pdp.commerceCard.promotion.learnmore']}}
产品信息
CL488-68011
种属反应
宿主/亚型
分类
类型
克隆号
抗原
偶联物
激发/发射光谱
形式
纯化类型
保存液
内含物
保存条件
运输条件
产品详细信息
Immunogen sequence: MSLKLQASNV TNKNDPKSIN SRVFIGNLNT ALVKKSDVET IFSKYGRVAG CSVHKGYAFV QYSNERHARA AVLGENGRVL AGQTLDINMA GEPKPDRPKG LKRAASAIYS GYIFDYDYYR DDFYDRLFDY RGRLSPVPVP RAVPVKRPRV TVPLVRRVKT NVPVKLFARS TAVTTSSAKI KLKSSELQAI KTELTQIKSN IDALLSRLEQ IAAEQKANPD GKKKGDGGGA SGGGGGGGGS GGGGSGGGGG GGSSRPPAPQ ENTTSEAGLP QGEARTRDDG DEEGLLTHSE EELEHSQDTD ADDGALQ
靶标信息
In infectious mononucleosis, anti-EBNA-1 antibodies are produced which cross-react with multiple normal human proteins. The cross-reactivity is due to anti-gly/ala antibodies that cross-react with host proteins containing configurations like those in the EBNA-1 repeat. One such antigen is RALY which is a member of the heterogeneous nuclear ribonucleoprotein gene family.
仅用于科研。不用于诊断过程。未经明确授权不得转售。
篇参考文献 (0)
生物信息学
蛋白别名: Autoantigen p542; Heterogeneous nuclear ribonucleoprotein C-like 2; hnR; hnRNP; hnRNP associated with lethal yellow protein homolog; hnRNP core protein C-like 2; huRaly; hnRNP C3; N-terminus similar to huRNP C; MGC117312; RNA binding protein, autoantigenic (hnRNP-associated with lethal yellow homolog); RNA-binding protein (autoantigenic); RNA-binding protein (autoantigenic, hnRNP-associated with lethal yellow); RNA-binding protein Raly; unnamed protein product
基因别名: HNRPCL2; P542; RALY
UniProt ID: (Human) Q9UKM9
Entrez Gene ID: (Human) 22913